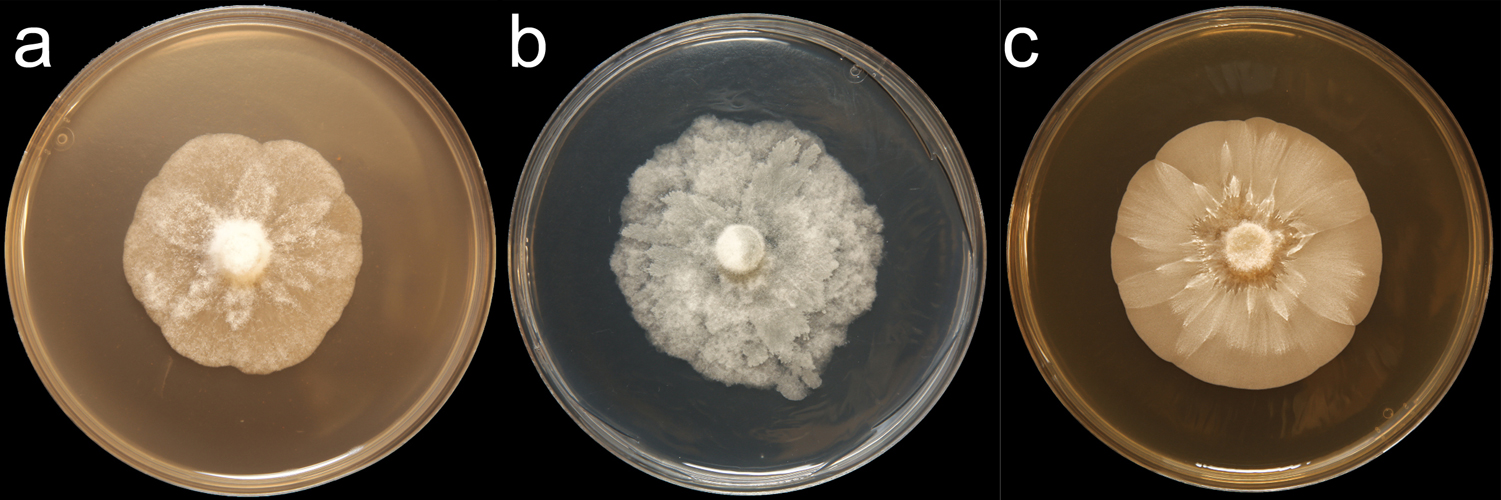

Phytophthora morindae
|
Phytophthora spp. in subclade 10a: portion of the seven-loci ML phylogeny featuring the type cultures of 212 described species (by T. Bourret). Notice the position of P. morindae Ex-type CBS 121982 = S&T BL 49G. Gloria Abad, USDA S&T.
|
|
Phytophthora spp. in subclade 10a: Morphological Tabular key (PDF) and Tabular key legends (PDF) in IDphy2 KEY SECTION. Notice the data of P. morindae Ex-type CBS 121982 = S&T BL 49G. Gloria Abad, USDA S&T.
|
|
Phytophthora morindae (CPHST BL 49G) colonies of the ex-type grown for 7 days on (a) V8® Agar, (b) potato dextrose agar, and (c) malt extract agar; photo by Krysta Jennings and Leandra Knight, USDA-APHIS-PPQ |
|
Phytophthora morindae (CPHST BL 49G, ex-type) asexual phase (a–i): sporangia produced in umbella type sporangiophores (a, b), sporangia papillated (c–i), caducous with short to medium pedicels (c–h), sometimes with two papilla (i); photos by Gloria Abad, USDA-APHIS-PPQ. |
|
Phytophthora morindae (CPHST BL 49G, ex-type) sexual phase (a–e): oogonia with tapered base (b–e), amphigynous antheridia (a–e), plerotic oospores (a–e), thick-walled when young (b–e); photos by Gloria Abad, USDA-APHIS-PPQ. |
|
Orchard-wide symptoms of black flag disease of noni (Morinda citrifolia) caused by Phytophthora morindae; photo by Scot Nelson, University of Hawaii at Manoa |
|
Leaf symptoms of black flag disease of noni (Morinda citrifolia) caused by Phytophthora morindae; photo by Scot Nelson, University of Hawaii at Manoa |
|
Leaf symptoms of black flag disease of noni (Morinda citrifolia) caused by Phytophthora morindae; photo by Scot Nelson, University of Hawaii at Manoa |
|
Fruit mummy symptoms of black flag disease of noni (Morinda citrifolia) caused by Phytophthora morindae; photo by Scot Nelson, University of Hawaii at Manoa |
|
Symptoms of black flag disease of noni (Morinda citrifolia) caused by Phytophthora morindae; photo by Scot Nelson, University of Hawaii at Manoa |
|
Phytophthora morindae (CPHST BL 49G, ex-type) asexual phase: caducous papillate sporangium with medium pedicel; photo by Gloria Abad, USDA-APHIS-PPQ. |
|
Phytophthora morindae (CPHST BL 49G, ex-type) asexual phase: caducous papillate sporangium with medium pedicel; photo by Gloria Abad, USDA-APHIS-PPQ. |
|
Phytophthora morindae (CPHST BL 49G, ex-type) asexual phase: caducous papillate sporangia with medium pedicels; photo by Gloria Abad, USDA-APHIS-PPQ. |
|
Phytophthora morindae (CPHST BL 49G, ex-type) asexual phase: caducous papillate sporangium with short pedicel; photo by Gloria Abad, USDA-APHIS-PPQ. |
|
Phytophthora morindae (CPHST BL 49G, ex-type) asexual phase: sporangia produced in umbella type sporangiophores, sporangia papillated; photo by Gloria Abad, USDA-APHIS-PPQ. |
|
Phytophthora morindae (CPHST BL 49G, ex-type) asexual phase: caducous bipapillate sporangium with medium pedicel; photo by Gloria Abad, USDA-APHIS-PPQ. |
|
Phytophthora morindae (CPHST BL 49G, ex-type) asexual phase: caducous papillate sporangium with medium pedicel; photo by Gloria Abad, USDA-APHIS-PPQ. |
|
Phytophthora morindae (CPHST BL 49G, ex-type) asexual phase: sporangia produced in umbella type sporangiophores, sporangia papillated; photo by Gloria Abad, USDA-APHIS-PPQ. |
|
Phytophthora morindae (CPHST BL 49G, ex-type) asexual phase: sporangia produced in umbella type sporangiophores, sporangia papillated; photo by Gloria Abad, USDA-APHIS-PPQ. |
|
Phytophthora morindae (CPHST BL 49G, ex-type) asexual phase: caducous papillate sporangium with medium pedicel; photo by Gloria Abad, USDA-APHIS-PPQ. |
|
Phytophthora morindae (CPHST BL 49G, ex-type) asexual phase: caducous papillate sporangium with medium pedicel; photo by Gloria Abad, USDA-APHIS-PPQ. |
|
Phytophthora morindae (CPHST BL 49G, ex-type) sexual phase: young plerotic oospore with thick wall, oogonium with tapered base and amphigynous antheridium; photo by Gloria Abad, USDA-APHIS-PPQ. |
|
Phytophthora morindae (CPHST BL 49G, ex-type) sexual phase: young plerotic oospore with thick wall, oogonium with tapered base and amphigynous antheridium; photo by Gloria Abad, USDA-APHIS-PPQ. |
|
Phytophthora morindae (CPHST BL 49G, ex-type) sexual phase: oospore with thick wall, oogonium with tapered base and amphigynous antheridium; photo by Gloria Abad, USDA-APHIS-PPQ. |
|
Phytophthora morindae (CPHST BL 49G, ex-type) sexual phase: young plerotic oospore with thick wall, oogonium with tapered base and amphigynous antheridium; photo by Gloria Abad, USDA-APHIS-PPQ. |
Name and publication
Phytophthora morindae Abad & S.C. Nelson (2010)
Nelson S and Abad ZG. 2010. Phytophthora morindae, a new species causing black flag on noni (Morinda citrifolia L) in Hawaii. Mycologia 102: 122–134.
Corresponding author: gloria.abad@aphis.usda.gov
Nomenclature
from Nelson and Abad (2010)
Mycobank
Etymology
refers to the host Morinda citrifolia L.
Typification
Type: UNITED STATES OF AMERICA, from Hawaii, Island of Hawaii, from Morinda citrifolia var. citrifolia (Indian mulberry, noni), Rubiaceae (Coffee family) infected with black flag disease of noni in the Puna District (Noni Farm Road), 10 Oct 2005, collector Scot C. Nelson P238; G. Abad isolate Ph697, BPI 878721 (dried culture on baby carrot agar)
Ex-type: CBS 121982 (P238, Ph697)
Sequences for ex-type in original manuscript: Ph697, P238: ITS rDNA FJ469147, EF-1a FJ469148
Ex-type in other collections
(ET) CBS 121982, WPC P19748, S&T BL 49G (Abad), 62B5 (Hong), Ph697 (Abad), P238 (Nelson)
Molecular identification
Voucher sequences for barcoding genes (ITS rDNA and COI) of the ex-type (see Molecular protocols page)
Phytophthora morindae isolate CPHST BL 49G (= P19748 WPC) = ITS rDNA MG865543, COI MH136936
Voucher sequences for Molecular Toolbox with seven genes (ITS, β-tub, COI, EF1α, HSP90, L10, and YPT1
(see Molecular protocols page) (In Progress)
Voucher sequences for Metabarcoding High-throughput Sequencing (HTS) Technologies [Molecular Operational Taxonomic Unit (MOTU)]
(see Molecular protocols page) (In Progress)
Sequences with multiple genes for ex-type in other sources
- NCBI: Phytophthora morindae CPHST BL 49G
- NCBI: Phytophthora morindae Ph697, P238
- EPPO-Q-bank: Phytophthora morindae CBS 121982
- BOLDSYSTEMS: Phytophthora morindae (barcoding COI & ITS)
Position in multigenic phylogeny with 7 genes (ITS, β-tub, COI, EF1α, HSP90, L10, and YPT1)
Clade 10a
Morphological identification
Colonies and cardinal temperatures
Colony colony:
assemblage of hyphae which usually develops form a single source and grows in a coordinated way
morphology on potato dextrose agar and malt extract agar with chrysanthemum to rosette pattern, colonies on V-8 agar with fine chrysanthemum pattern. Minimum for growth 6°C, optimum 21–25°C, maximum 27°C.
Conditions for growth and sporulation
Abundant sporangiasporangia:
sac within which zoospores form, especially when water is cooled to about 10°C below ambient temperature; in solid substrates, sporangia usually germinate by germ tubes
and oogoniaoogonia:
the female gametangium in which the oospore forms after fertilization by the antheridium
produced in culture media.
Asexual phase
SporangiaSporangia:
sac within which zoospores form, especially when water is cooled to about 10°C below ambient temperature; in solid substrates, sporangia usually germinate by germ tubes
papillatepapillate:
pertaining to the production of a distinct papilla at the distal end of the sporangium (cf. nonpapillate and semipapillate)
, occasionally bipapillate; caducouscaducous:
pertaining to sporangia that become dislodged readily (i.e. deciduous) and separate from the sporangiophore (cf. persistent)
with medium to long pedicels (8–66 µm); ellipsoidellipsoid:
refers to a solid body that forms an ellipse in the longitudinal plane and a circle in cross section; many fungal spores are ellipsoidal or elliptic
(sometimes with tapered basetapered base:
pertaining to the base of a sporangium or oogonium; funnel-shaped
), obpyriformobpyriform:
inversely pear-shaped, i.e. with the widest part at the point of attachment (cf. pyriform)
, limoniform, or asymmetrical (bilaterally symmetrical or mouse-shaped with one rounded and one flatter side) (30–54 L x 19–24 W µm); originated in umbellate sporangiophores. Hyphal swellings absent. ChlamydosporesChlamydospores:
an asexual spore with a thickened inner wall that is delimited from the mycelium by a septum; may be terminal or intercalary, and survives for long periods in soil
absent.
Sexual phase
Homothallic. Oogonia smooth-walled and frequently with tapered basetapered base:
pertaining to the base of a sporangium or oogonium; funnel-shaped
(22–40 µm diam.); antheridiaantheridia:
the male gametangium; a multinucleate, swollen hyphal tip affixed firmly to the wall of the female gametangium (the oogonium)
amphigynous amphigynous:
pertaining to the sexual stage in which the antheridium completely surrounds the stalk of the oogonium (cf. paragynous)
(7–14 L x 6–12 W µm); oosporesoospores:
zygote or thick-walled spore that forms within the oogonium after fertilization by the antheridium; may be long-lived
pleroticplerotic:
pertaining to an oospore that fills the oogonium (cf. aplerotic)
(21–39 µm diam.) with wall thickness 2.4–3.6 µm, immature oosporesoospores:
zygote or thick-walled spore that forms within the oogonium after fertilization by the antheridium; may be long-lived
showing the presence of thick walls and mature oosporesoospores:
zygote or thick-walled spore that forms within the oogonium after fertilization by the antheridium; may be long-lived
showing thinner walls; large ooplasts in mature oosporesoospores:
zygote or thick-walled spore that forms within the oogonium after fertilization by the antheridium; may be long-lived
frequently present (13–20 µm diam.).
Most typical characters
The morphology of sexual reproductive structures of Phytophthora kernoviae are similar, but the umbellate sporangiophores of P. morindae differentiate it from P. kernoviae.
Specimen(s) evaluated
Phytophthora morindae ex-type CPHST BL 49G, duplicate of P19748 (World Phytophthora Collection), which is a duplicate of ex-type CBS 121982
Hosts and distribution
Distribution: USA: HI
Substrate: leaves, petioles, pedicelpedicel:
the hyphal base of a sporangium that remains attached after the sporangium separates, or is shed, from the sporangiophore; the pedicel may be short (< 5 µm), medium (5–20 µm), or long (> 20 µm)
, fruit
Disease note: black flag disease
Host: Morinda citrifolia var. citrifolia (Rubiaceae)
Retrieved January 31, 2018 from U.S. National Fungus Collections Nomenclature Database.
Additional info
Phytophtora morindae has been reported only on Morinda citrifolia var. citrifola in Hawaii, where it is capable of causing blight on aboveground plant parts (root and stem tissue have not shown symptoms or the ability to recover the pathogen). Severely infected plants have a characteristic black flag consisting of diseased leaves. In the early stages of disease the leaves may have black streaks alongside the veins caused by rapid colonization by the pathogen. Fruit infection often occurs through the pedicelpedicel:
the hyphal base of a sporangium that remains attached after the sporangium separates, or is shed, from the sporangiophore; the pedicel may be short (< 5 µm), medium (5–20 µm), or long (> 20 µm)
and can result in shriveled fruit mummies remaining attached to the stem.
Additional references and links
- SMML USDA-ARS: Phytophthora morindae
- EPPO Global Database: Phytophthora morindae
- Forest Phytophthora of the world: Phytophthora morindae
- CABI Digital Library: Phytophthora morindae
- Encyclopedia of Life (EOL): Phytophthora morindae
- Index Fungorum (IF): Phytophthora morindae
- Google All Phytophthora morindae
- Google Images Phytophthora morindae
- Google Scholar Phytophthora morindae
Fact sheet author
Z. Gloria Abad, Ph.D., USDA-APHIS-PPQ-S&T Plant Pathogen Confirmatory Diagnostics Laboratory (PPCDL), United States of America.